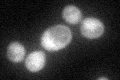
YDR051C
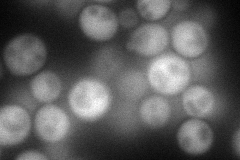
YDR051C
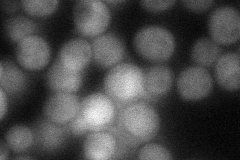
YDR051C
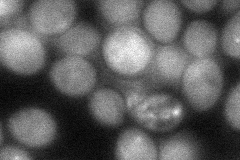
YDR051C

View description
Acid phosphatase involved in the non-vesicular transport of sterols in both directions between the endoplasmic reticulum and plasma membrane; deletion confers sensitivity to nickel
Localization:
Intensity:
Fold change:
Significance:
-
C’ GFP library in SD
cytosol34.65 -
N' NOP1pr-GFP in SD
cytosol106.609 -
N' TEF2pr-mCherry in SD

cytosol150.822 -
N' NATIVEpr-GFP in SD
cytosol54.0357 -
N' TEF2pr-VC and Cyto-VN in SD
cytosol53.5947 -
C’ GFP library in SD+DTT

cytosol33.850.97No -
C’ GFP library in SD+H2O2

cytosol32.790.94No -
C’ GFP library in Starvation Media

cytosol33.160.95No -
C’ GFP library on the background of Pup2-DaMP

cytosol -
C’ GFP library on the background of CCT mutant

cytosol41.0791.18525No
